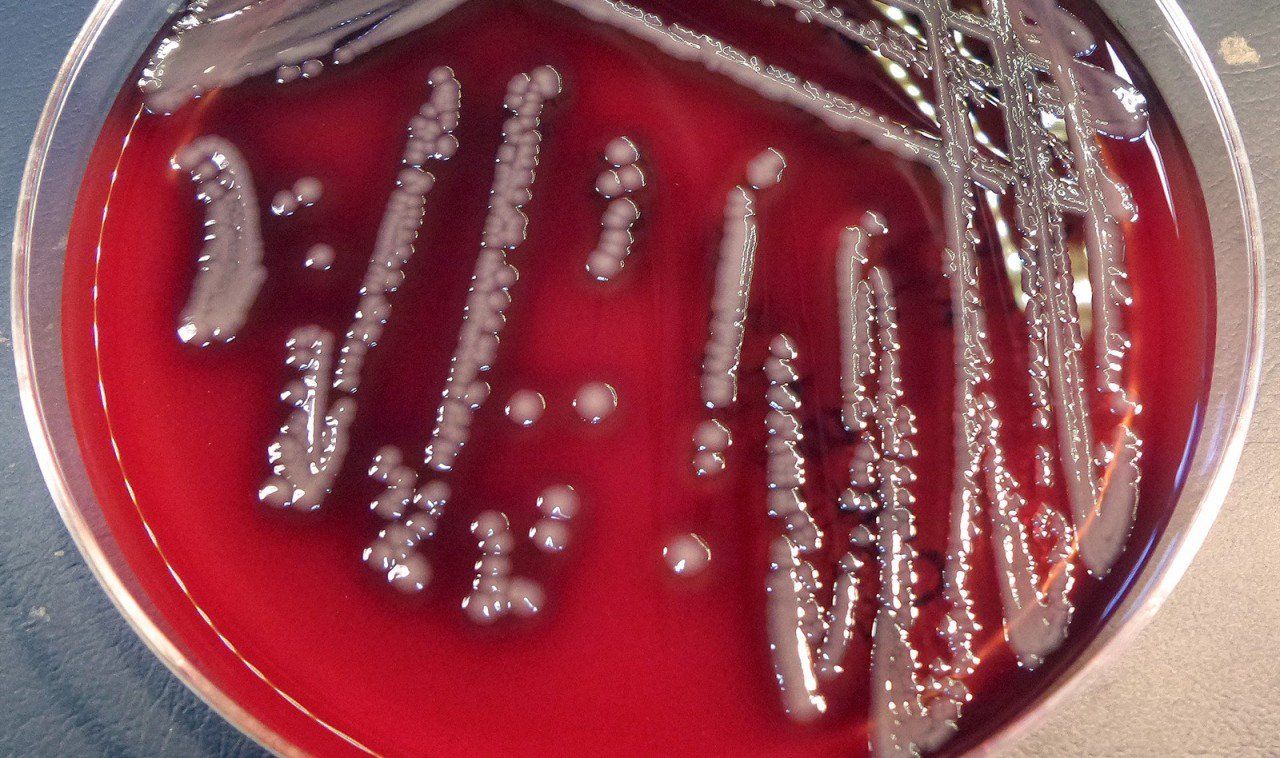
Aeromonas hydrophila có phải vi khuẩn ăn thịt người?

Aeromonas hydrophila có phải vi khuẩn ăn thịt người?


1. Vi khuẩn aeromonas hydrophila là gì?
Vi khuẩn Aeromonas hydrophila (AH) là loại trực khuẩn gram âm, có khả năng gây bệnh nặng tương tự những loại trực khuẩn gram âm khác gồm vi khuẩn hoại thư sinh hơi, Shigella, Salmonella, Escherichia coli, Pseudomonas aeruginosa... Về hình dạng vi khuẩn Aeromonas hydrophila có hình que, có kích thước khoảng từ 0,5 - 1 micrometer chiều rộng và 1 - 3 micrometer chiều dài.
Về môi trường sinh sống, vi khuẩn Aeromonas hydrophila trú ngụ chủ yếu ở môi trường nước ấm và cả vùng nước lợ ven biển tại các khu vực nhiệt độ nóng ẩm. Chúng tiết ra ngoại độc tố giống vi khuẩn Vibrio cholerae gây bệnh tả nên khi bị mắc bệnh sẽ có ảnh hưởng đến đường tiêu hóa và có triệu chứng lâm sàng của bệnh tả thể nhẹ.
Vi khuẩn Aeromonas hydrophila thường hiện diện trong nước ngọt hoặc nước lợ bẩn, nước bùn lầy hoặc cống rãnh... và gây bệnh cho các loài tôm, cá, ếch, nhái, bò sát là chủ yếu; trong những trường hợp người có nguy cơ cao như da bị vết cắt, trầy xước, mụn nhọt, lở loét... có tiếp xúc với nguồn nước bẩn thì có nguy cơ nhiễm bệnh.
2. Con đường lây của vi khuẩn aeromonas hydrophila
Nếu uống phải nước bẩn có vi khuẩn Aeromonas hydrophila hay do ngoại độc tố của chúng tiết ra, sau khi qua đường ruột chúng có thể gây ra nguy cơ nhiễm trùng huyết và suy đa phủ tạng, thường dễ xảy ra ở nhóm người đang bị suy giảm miễn dịch.
Nếu bị nhiễm qua da, vi khuẩn Aeromonas hydrophila xâm nhập vết thương gây viêm hoại tử da, cân cơ, cơ; gây nhiễm trùng huyết, suy đa phủ tạng với nguy cơ tử vong cao; đồng thời có thể dẫn đến nhiễm trùng đường mật nguy cơ nhiễm trùng huyết dễ xảy ra nếu người mắc có tiền sử xơ gan và đang suy giảm miễn dịch.
Sau khi thâm nhập vào cơ thể thông qua các vết thương trên da, vi khuẩn Aeromonas hydrophila vào máu, tới các mô mềm hoặc các cơ quan trong cơ thể, nhân lên và gây bệnh thông qua nội độc tố là aerolysin. Độc tố này gắn vào một số cơ quan cảm thụ tại vách tế bào vật chủ làm tế bào bị tổn thương và hoại tử mô.
Để chẩn đoán xác định do vi khuẩn Aeromonas hydrophila gây ra một cách chắc chắn, cần phải thực hiện xét nghiệm nuôi cấy bệnh phẩm, phân lập được vi khuẩn hoặc xác định vi khuẩn bằng kỹ thuật sinh học phân tử PCR (polymerase chain reaction).
3. Điều trị và phòng bệnh vi khuẩn aeromonas hydrophila
3.1. Điều trị bệnh vi khuẩn aeromonas hydrophila
- Sử dụng thuốc kháng sinh: Vi khuẩn Aeromonas hydrophila vẫn còn có thể nhạy cảm với các loại kháng sinh thông thường như sulfamid, chloramphenicol, tetracycline, ciprofloxacin...; tuy vậy chúng vẫn có khả năng kháng lại một số kháng sinh họ penicillin và cephalosporin.
- Sử dụng hóa chất diệt khuẩn: Vi khuẩn Aeromonas hydrophila cũng dễ dàng bị tiêu diệt bởi các loại hóa chất diệt khuẩn thông thường. Trên thực tế, mặc dù vi khuẩn còn nhạy cảm với nhiều loại kháng sinh và dễ dàng bị tiêu diệt với các loại hóa chất diệt khuẩn thông thường nhưng do bệnh thường diễn biến nhanh, người mắc dễ bị viêm hoại tử nhiều tổ chức, bộ phận của cơ thể do đó dễ dẫn đến tình trạng nhiễm trùng huyết, sốc nhiễm khuẩn, suy đa phủ tạng và thường chiếm tỷ lệ tử vong cao.
Hiện nay với sự trợ giúp của các phương tiện và kỹ thuật cấp cứu hồi sức hiện đại với hiệu quả đáp ứng cao nên có thể hạn chế bớt các trường hợp tử vong do vi khuẩn Aeromonas hydrophila gây ra. Tuy nhiên cần lưu ý rằng sau khi điều trị khỏi bệnh, người đã từng bị mắc bệnh do vi khuẩn Aeromonas hydrophila vẫn phải chịu những di chứng nặng nề do hậu quả biến chứng của bệnh để lại.

3.2. Dự phòng bệnh do vi khuẩn aeromonas hydrophila gây ra
- Không nên hoặc hạn chế tiếp xúc với nguồn nước bẩn nhất là khi trên da bị vết thương, vết cắt, trầy xước, lở loét, mụn nhọt...
- Nếu da bị tổn thương, cần xử lý sạch các vết cắt, vết thương làm rách da, mụn nhọt và vết trầy xước... bằng xà phòng và nước sạch; làm sạch tổn thương, để khô ráo, băng che lại vết thương bằng băng khô, sạch cho đến khi lành
- Vết thương sâu hoặc nghiêm trọng khác, cần đến cơ sở y tế để xử lý vết thương đúng quy định; trường hợp bị nhiễm nấm ở chân cũng phải được chăm sóc kỹ để tránh nguy cơ bội nhiễm vi khuẩn Aeromonas hydrophila.
- Vệ sinh môi trường nước sinh hoạt, không để nước bị nhiễm bẩn, nhiễm độc.
- Thực hiện tốt vệ sinh an toàn thực phẩm để phòng ngừa vi khuẩn Aeromonas hydrophila xâm nhập qua đường tiêu hóa.
- Cần sử dụng trang bị phòng hộ lao động phù hợp để bảo vệ với những người làm nghề thường xuyên phải tiếp xúc với môi trường nước.
- Khi có dấu hiệu nghi ngờ phải đến cơ sở y tế để được phát hiện sớm, nên cấy máu và thực hiện các xét nghiệm cần thiết xác định vi khuẩn Aeromonas hydrophila;
- Làm kháng sinh đồ để điều trị theo thuốc kháng sinh có hiệu quả ngay từ đầu trước khi quá muộn.

Ho rát họng có đờm là một vấn đề phổ biến có thể gặp ở bất kỳ ai. Nguyên nhân của tình trạng này có thể là viêm amidan, cảm cúm, viêm họng, thậm chí là ung thư vòm họng.
![[Góc giải đáp] Viêm Phế Quản Có Lây Không?](/uploads/suc-khoe/2023_12/viem-phe-quan-co-lay-khong.png&w=250&h=250&checkress=dccabc90558be2a987edc1d415786e89)
Viêm phế quản là một bệnh lý phổ biến trong xã hội ngày nay mà nhiều người có thể mắc phải. Tuy viêm phế quản không gây nguy hiểm đến tính mạng nhưng có thể ảnh hưởng đáng kể đến sức khỏe của người bệnh.

Ho, sốt đau họng là những triệu chứng thường gặp cùng lúc và có thể ảnh hưởng đến cuộc sống hàng ngày. Bài viết dưới đây sẽ làm rõ nguyên nhân, cách nhận biết và những phương pháp hiệu quả để giảm nhẹ và xua tan những triệu chứng này.

Là một phần quan trọng của hệ hô hấp, họng thường mắc phải nhiều bệnh lý khác nhau. Các bệnh về họng có thể đơn giản chỉ là viêm họng hoặc có thể nghiêm trọng hơn như viêm amidan, viêm thanh quản và thậm chí ung thư họng.

Thời điểm giao mùa, các trung tâm Y tế đang ghi nhận nhiều trường hợp bệnh nhi mắc viêm phổi do vi khuẩn Mycoplasma. Đây là một bệnh thường xuất hiện trong mùa giao mùa, đặc biệt làm lây lan nhanh chóng.
















